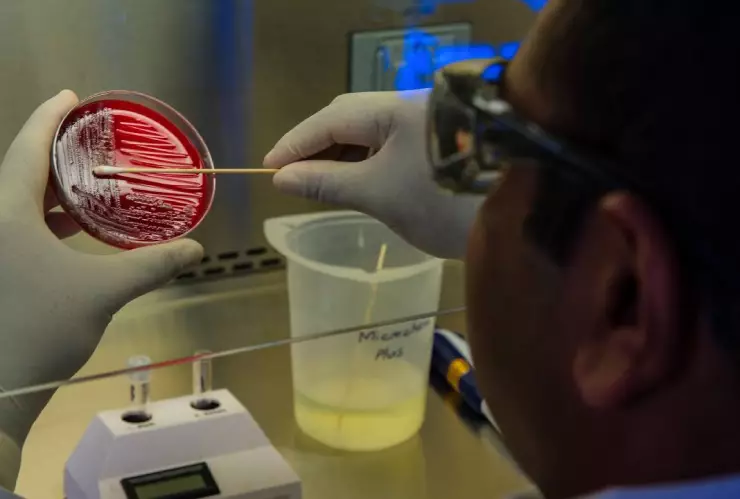
¿Qué es la bacteria Vibrio vulnificus y por qué le dicen come carne?

Ante la alerta en Estados Unidos por la presencia de la bacteria Vibrio vulnificus, a la que también se le conoce como ‘come carne’, los Centros de Control de Enfermedades de Estados Unidos (CDC por sus siglas en inglés, explicaron qué es qué tan peligrosa puede llegar a ser.
Se hizo un llamado a los doctores para considerar que este patógeno sería la causa de las heridas que fueron expuestas a aguas de la costa del Golfo de México o incluso en la costa Este norteamericana.
Síntomas de la bacteria Vibrio vulnificus
Las personas pueden experimentar diversos malestares, como por ejemplo:
- Diarrea
- Cólicos estomacales
- Náuseas
- Vómito
- Fiebre
Si la infección logra llegar al torrente sanguíneo, los pacientes podrían desarrollar lo siguiente:
- Escalofríos
- Fiebre
- Presión sanguínea baja
- Lesiones en la piel con ampollas
Es posible que las personas se contagien por infecciones en las heridas y estas, podrían experimentar:
- Fiebre
- Enrojecimiento
- Dolor
- Hinchazón
- Sensación de calor
- Decoloración
- Secreción de líquido desde la herida
Te puede interesar: Amputan extremidades a mexicana por comer tilapia contaminada con bacteria come carne
Enfermedad que produce la bacteria Vibrio vulnificus
Stay safe this summer! Vibrio bacteria live in the ocean and can get into skin through cuts or open wounds. If a wound gets worse after swimming in salty or brackish water, seek medical attention. https://t.co/8gbbaowzav pic.twitter.com/7lD3bgznV7
— CDC (@CDCgov) August 13, 2019
Esta bacteria es capaz de provocar Vibriosis, que es una
enfermedad
que dura tres días en casos leves, pero para quienes desarrollen un cuadro grave, el tratamiento tendría que ser aplicados en un hospital, ya que el paciente puede caer en cuidados intensivos.
- Algunas formas en las que las personas se pueden contagiar, son las siguientes:
- Comer ostras, pescados y mariscos poco cocidos o curdos
- Nadar en aguas contaminadas teniendo heridas abiertas
Los expertos explicaron que la bacteria Vibrio Vulnificus puede desarrollar fascitis necrosante, que es una infección en donde la carne de los pacientes empieza a morir alrededor de una herida abierta. Es importante mencionar que este mal puede ser causado por otras bacterias.
En personas que desarrollen casos graves, pueden perder una extremidad para evitar perder la vida y es que casi una de cada cinco personas muere cuando contrae esta infección.
¿Quieres mantenerte informado o enviarnos tu reporte ciudadano? Síguenos en
Facebook
,
X
,
Instagram
y
TikTok
.
También puedes disfrutar de la programación en vivo de
Azteca UNO
y
Azteca 7